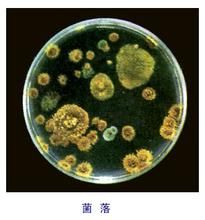
菌落 菌落

簡介
在血瓊脂平板上的典型菌落通常是細菌在固體培養基上(內)生長發育,形成以母細胞為中心的一團肉眼可見的、有一定形態、構造等特徵的子細胞的集團,稱之為菌落。
培養
菌落將分散的細胞或孢子被稀釋到一定程度,接種到培養基上,在一定培養條件下,使其生長繁殖。由於細胞受到固體培養基表面或深層的限制,子代菌體常以母細胞為中心聚集在一起,形成具有一定形態結構的子細胞群體。每個能夠生長繁殖的細菌細胞都可以在平板上形成一個可見的菌落。
如果細菌菌體接種於半固體培養基中或液體培養基中,是不能形成菌落的。在半固體培養基中,接種的無鞭毛的細菌只沿著穿刺線生長,而有鞭毛的細菌可在穿刺線的周圍擴散生長。
細菌菌體接種於液體培養基中,細菌生長後能使液體培養基變得混濁。混濁情況視細菌對氧氣需求的不同而有所不同:好氧菌僅使上部培養液混濁,厭氧菌使底部培養液混濁,兼性厭氧菌使培養液上下均勻混濁;有的細菌可在培養液表面形成菌環或菌膜,或在底部產生沉澱。操作方法
根據標準要求或對污染情況的估計,選擇2~3個適宜稀釋度,分別在制10倍遞增稀釋的同時,以吸取該稀釋度的吸管移取1ml稀釋液於滅菌平皿中,每個稀釋度做兩個平皿。將涼至46℃營養瓊脂培養基注入平皿約15ml,並轉動平皿,混合均勻。同時將營養瓊脂培養基傾入加有1ml稀釋液(不含樣品)的滅菌平皿內作空白對照。待瓊脂凝固後,翻轉平板,置36±1℃溫箱內培養48±2h,取出計算平板內菌落數目,乘以稀釋倍數,即得每克(每毫升)樣品所含菌落總數。
操作要點
1.傾注用培養基應在46℃水浴內保溫,溫度過高會影響細菌生長,過低瓊脂易於凝因而不能與菌液充分混勻。如無水浴,應以皮膚感受較熱而不燙為宜。傾注培養基的量規定不一,從12~20ml不等,一般以15ml較為適宜,平板過厚可影響觀察,太薄又易於乾裂。傾注時,培基底部如有沉澱物,應將底部棄去,以免與菌落混淆而影響計數觀察。
2.為使菌落能在平板上均勻分布,檢液加入平皿後,應儘快傾注培養基並鏇轉混勻,可正反兩個方向鏇轉,檢樣從開始稀釋到傾注最後一個平皿所用時間不宜超過20min,以防止細菌有所死亡或繁殖。
3.培養溫度一般為37℃(水產品的培養溫度,由於其生活環境水溫較低,故多採用30℃)。培養時間一般為48h,有些方法只要求24h的培養即可計數。培養箱應保持一定的濕度,瓊脂平板培養48h後,培養基失重不應超過15%。
4.為避免食品中的微小顆粒或培基中的雜質與細菌菌落髮生混淆,不易分辨,可同時作一稀釋液與瓊脂培基混合的平板,不經培養,而於4℃環境中放置,以便計數時作對照觀察。在某些場合,為了防止食品顆粒與菌落混淆不清,可在營養瓊脂中加入氯化三苯四氮唑(TTC),培養後菌落呈紅色,易於分別。
注意事項
1.操作要快而準,包括材料、加樣、倒培養基。
2.吸液體時液體不能進入吸頭。
3.樣品稀釋時一定要混勻。
4.倒培養基前,瓶口要過火焰。
5.一定要有空白對照。
6.培養基溫度控制,培養基薄厚。
7.檢測時一定要使平皿完全暴露於空氣中。
特徵和形態
大腸桿菌在去氧膽酸鹽瓊脂上的形態細胞形態是菌落形態的基礎,菌落形態是細胞形態在群體集聚時的反映。細菌是原核微生物,故形成的菌落也小;細菌個體之間充滿著水分,所以整個菌落顯得濕潤,易被接種環挑起;球菌形成隆起的菌落;有鞭毛細菌常形成邊緣不規則的菌落;具有莢膜的菌落表面較透明,邊緣光滑整齊;有芽孢的菌落表面乾燥皺褶;有些能產生色素的細菌菌落還顯出鮮艷的顏色。
大腸桿菌在普通瓊脂培養基上面都是一樣的,圓形邊緣整齊,表面光滑,半透明,小凸起;典型的大腸桿菌在伊紅美藍瓊脂平板上的特徵為:深紫黑色、光滑、濕潤、帶有金屬光澤的圓形菌落。